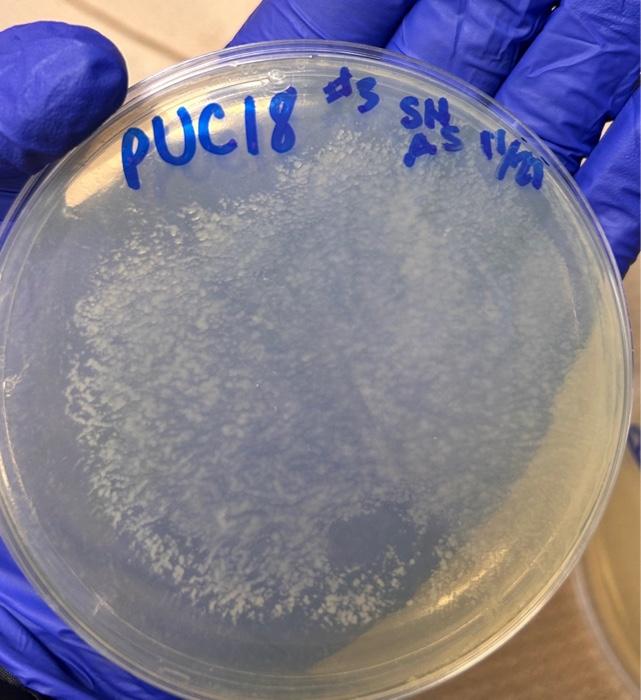
Solved 2. What are the 2 major features of plasmid? (0.5) 3. | Chegg.com

In addition to the information above, here is a curated collection of images related to Figure 3 From The Highly Diverse Plasmid Population Found In.
- Solved You Are Given A Plasmid That Could Be One Of Three | Chegg.Com
- Solved 2. What Are The 2 Major Features Of Plasmid? (0.5) 3. | Chegg.Com
- Solved You Have Been Given A New DNA Plasmid Called Plasmid | Chegg.Com
- Plasmid Constructs Used To Analyze The Importance Of Segments In 3′ U3 ...
- Plasmid Background Images, HD Pictures And Wallpaper For Free Download ...
Find More About "Figure 3 From The Highly Diverse Plasmid Population Found In"
Explore exclusive offers, detailed information, and related services about figure 3 from the highly diverse plasmid population found in from our trusted partners.
View Special Offers